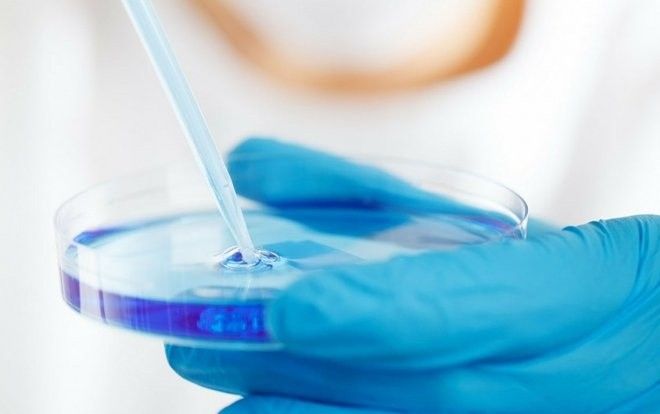
Hy hữu: Chồng bồi thường hơn 100 triệu cho vợ vì tự ý hủy lưu trữ phôi lạnh

Tìm kiếm từ khoá
#cặp vợ chồng
Saostar cập nhật tin tức, sự kiện, hình ảnh, video clip hot nhất 24h qua về chủ đề cặp vợ chồng


Mẹo nhỏ giúp các cặp đôi thăng hoa trong đời sống vợ chồng, đặc biệt là dịp Tết

Hà Nội: Sau tiếng nổ cực lớn, ngọn lửa bao trùm căn phòng trọ nơi cặp vợ chồng sinh sống

Xôn xao cặp vợ chồng chở nhau đi ly hôn mà ôm eo, cười híp mắt như đi hưởng trăng mật

Xem xét xử lý vi phạm cặp vợ chồng F0 từ TP HCM ra Hà Nội di chuyển tiếp xúc nhiều

Thừa Thiên - Huế tạm dừng điều tiết nước tại thủy điện để tìm kiếm đôi vợ chồng mất tích trên sông

Đang đạp xe về nhà, người phụ nữ bị nhóm đàn ông chặn đường giở trò đồi bại trước mặt chồng

Lấy chồng gần nhà, con gái về 'ăn chực' mỗi ngày, biểu cảm của bố mẹ khiến dân mạng cười nắc nẻ
.png)
Hotgirl đăng ảnh hôn chồng 62 tuổi khiến dân mạng chỉ trích nặng nề, nhưng sự thật là điều bất ngờ
.png)
Cặp đôi bỏ rơi con gái 2 tháng tuổi đến chết giữa cánh đồng vì 'không có tình cảm'
.jpg)
Vợ chồng HaHa và Buyl đính chính về tin đồn đi làm thủ thuật để không sinh thêm con

Những cặp vợ chồng khiến dân tình tá hỏa vì tướng phu thê: Hari - Trấn Thành giống nhau nhưng chưa bằng trùm cuối

4 ngày sau đám cưới, cặp vợ chồng trẻ cùng chết tức tưởi vì hố 'tử thần'

Vợ chồng 50 năm sống biệt lập giữa rừng Quảng Trị

Bộ ảnh cover 'Gửi anh xa nhớ' của cặp vợ chồng Sài thành gây sốt 'rần rần'
Hy hữu: Chồng bồi thường hơn 100 triệu cho vợ vì tự ý hủy lưu trữ phôi lạnh

Cặp vợ chồng lừa 93 tỷ của nhiều đại gia Sài Gòn

Chuyện tình cảm động: Cưới nhau 80 năm mới có bộ ảnh cưới đúng nghĩa

Cặp vợ chồng kết hôn gần 100 năm vẫn sống hạnh phúc khiến nhiều đôi ngưỡng mộ
